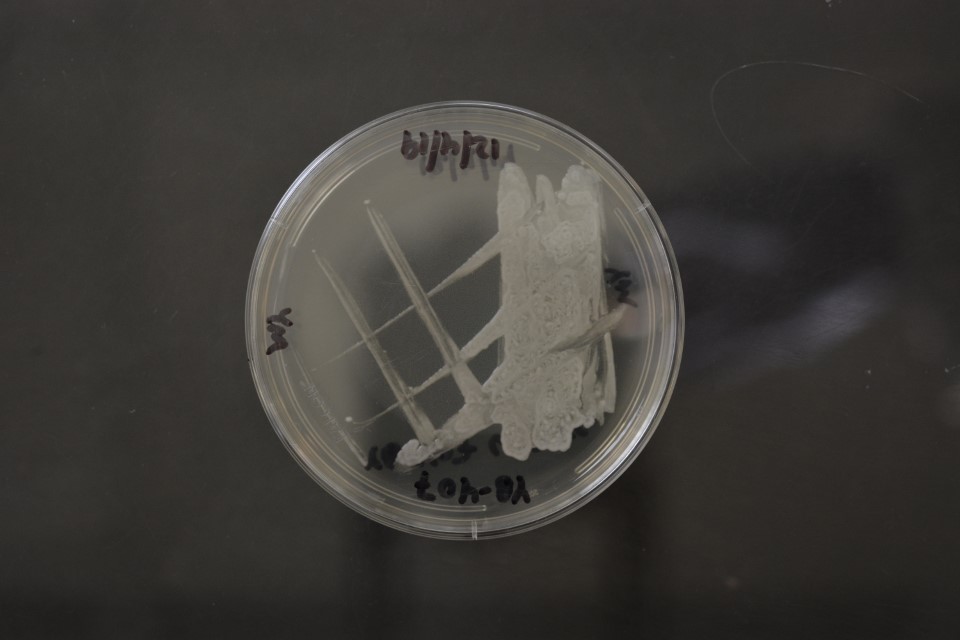

Komagataella ulmi
NRRL YB-407(Type Strain)
Accession numbers in other collections:CBS 12361
Source:L.Wickerham,NRRL
Isolated from(substrate):FX,slime flux,Elm tree(Ulmus americana)
Substrate location:Peoria,IL,USA
Genetic info:ID by Robnett,0 diff.D1/D2 with YB-495 and 6 diff.D1/D2 with Y-7556(Komagataella phaffii).GenBank:D1/D2(JN234403)(KF964140),SSU(KF964125),EF-1 alpha(JN234407),RPB1(JN234409),RPB2(KF977603),ITS(JQ398746),mito SSU(JN234405).
Growth media:Yeast Extract-Malt Extract-Peptone-Glucose(YM for yeasts)(number 6)
Optimum growth temperature:25C
Strain images:
NRRL_YB-407_6.JPG